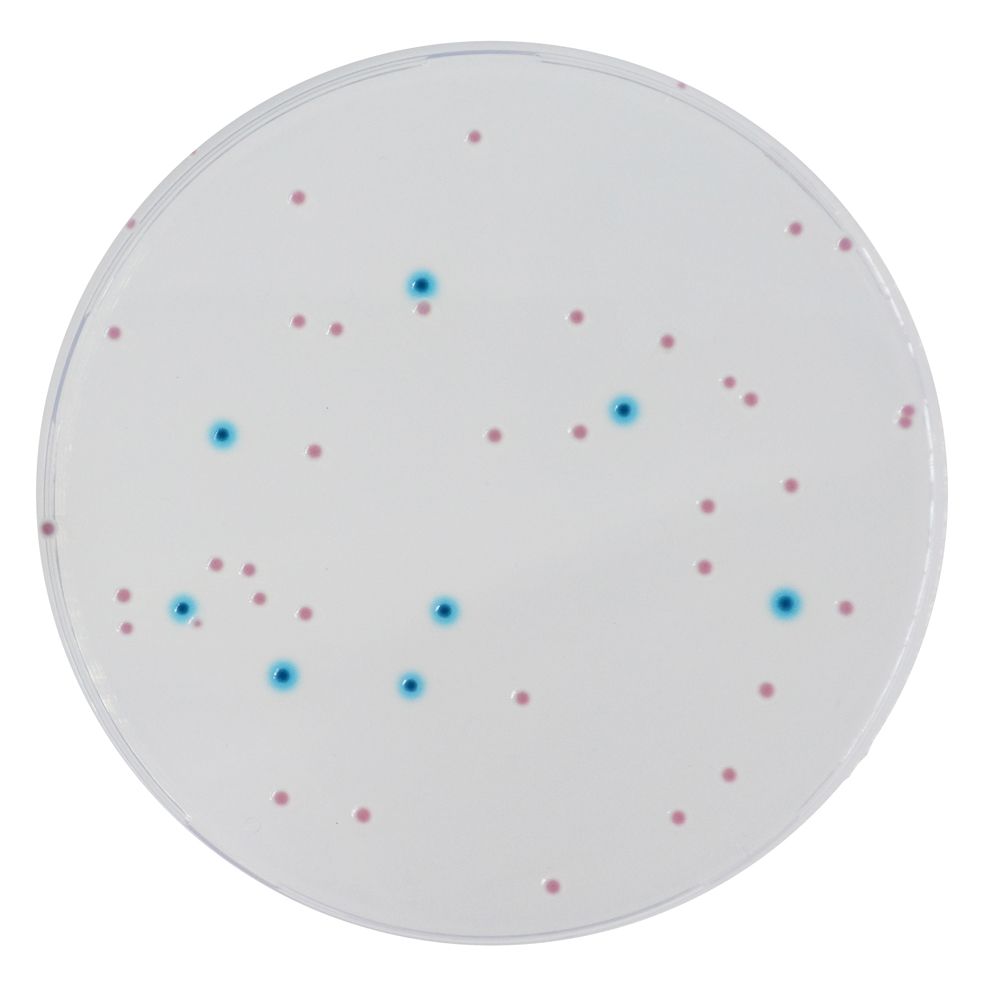

TT100L
Extra supplement for CHROMagar™ media (to be used with extra supplement CV720, with ready-to-use bottles only)
Package size: 100 L
DKK 300,00
DKK 2.250,00
In stock, delivery 1-2 days
Chromogenic medium for detection and enumeration of Enterobacteriaceae.
The product is composed of one powder Base (B).
Two optional supplements are availabe to be used with ready-to-use bottles (S1/TT100L as a liquid and S2/CV702 as a powder).
MEDIUM PERFORMANCE:
1. Easy differentiation between E. coli and other Enterobacteriaceae by the color, unlike with VRBG.
2. Easy reading:the intense colored colonies on a clear agar background facilitate the reading, contrary to VRBG, where the small background allows little contrast.
TYPICAL APPEARANCE OF MICROORGANISMS:
E. coli → blue
Other Enterobacteriaceae → pink to red
Acoorrding to ILSI Europe (International Life Sciences Institute): "The Enterobacteriaceae and coliform bacteria within this family represent two of the most common groups of indicator organism used by the food industry. In some countries, depending on regulatory requirements, the food industry has moved towards testing for Enterobacteriaceae."
The ISO 21528 specifies a method for the enumeration of Enterobacteriaceae, applicable to products intended for human consumption, feeding of animals, and environmental samples using VRBG as culture medium.
CHROMagar™ Enterobacteria allows de detection and differentiation by the color of E. coli and other Enterobacteria.
Supplements for ready-to-use bottles are available in 5000 ml (CV702) and 100 L (TT100L).